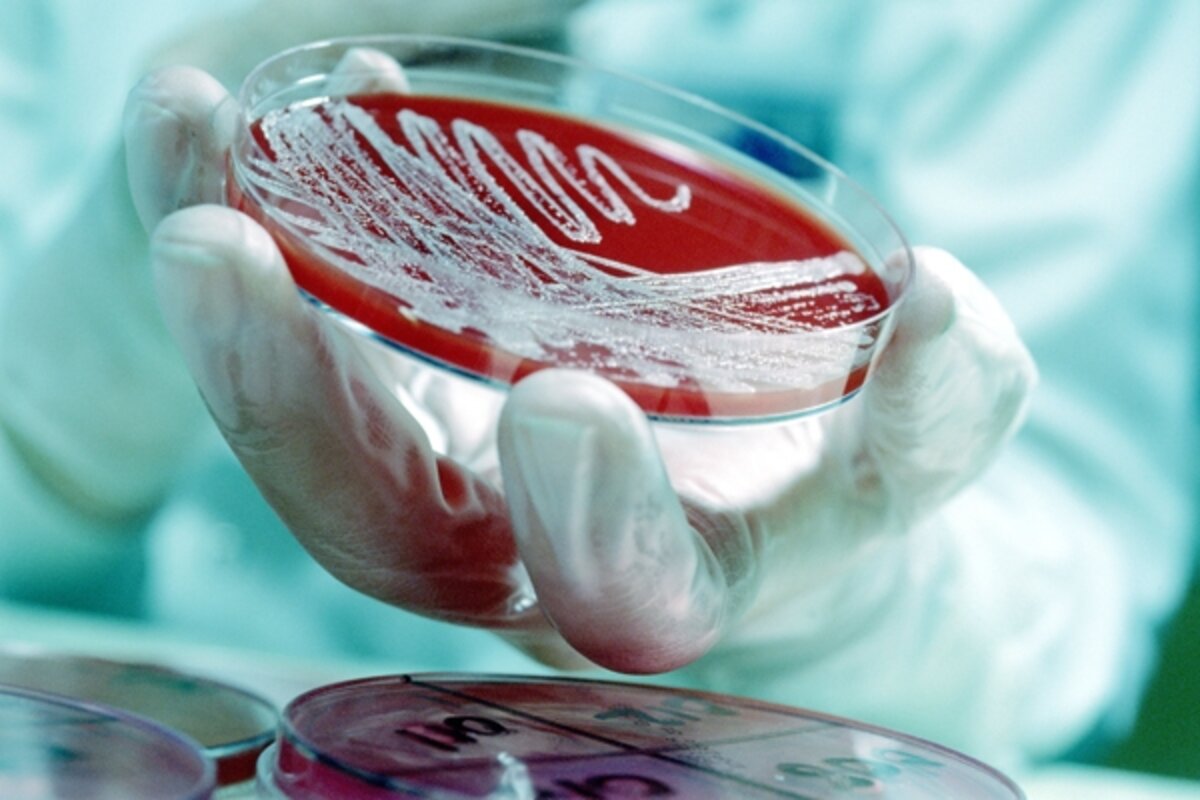

Microscopic objects may lead to large pollution solution
Loading...
Scientists are forging a new partnership with bacteria. They call it metabolic engineering. Microbes are the most sophisticated chemists on Earth. We have used them for thousands of years to make fermented foods and, more recently, in some chemical manufacturing processes. Now microbial scientists want to carry that partnership to a new level. They are gaining a deeper understanding of microbes’ metabolic chemical skills with an eye to using those skills more effectively, and even reengineering them, to serve human purposes. These include making biofuels, cleaning up pollutants, even removing CO2 from the air.
Reports of research from two universities last month reflect that ambition. Kristala Prather at the Massachusetts Institute of Technology summed up these efforts succinctly, saying, “We’re trying to ask what kinds of things should we be trying to make, and looking for possible routes in nature to make them.”
Professor Prather is developing bacteria to turn agricultural byproducts into butanol and pentanol for biofuel. Her colleague Gregory Stephanopoulos is trying to engineer bacteria that can better tolerate toxins that accompany the fuel-producing fermentation.
Bacteria also can help in making textiles and plastics. Prather is developing bacteria to produce starting materials for biodegradable plastics. The MIT announcement explains that bacteria-assisted manufacturing can save energy. Bacteria thrive in room temperature and normal atmospheric pressure while most industrial chemistry needs energy-intensive high temperatures and pressures.
Meanwhile, MIT’s Catherine Drennan is working with bacteria that break down carbon monoxide and carbon dioxide. Some of them break down an estimated 1 billion tons of carbon monoxide in the environment each year, according to scientists at MIT. Professor Drennan wonders, “Can we use this chemistry to do the same thing?” That means understanding the nitty-gritty of how the bacteria’s chemistry works. Her team hopes to gain that understanding by deciphering the exact structure of the enzymes involved.
Drennan adds that “if you’re going to borrow ideas from nature, the first step is to understand how nature works.”
Even after that knowledge is gained, it won’t necessarily be easy to adapt it for human purposes.
“Biology has a lot of diversity that’s untapped and undiscovered,” Prather explains, “but the flip side is that it’s hard to engineer in precise ways. Nature has evolved to do what it does, and to get it to do something different is a nontrivial task.”
Knowing more about how bacteria gained chemical skills in the first place can help in that quest. Last month, Science published research that shows bacteria probably had evolved their main chemical skills 2.5 billion years ago. While countless bacterial species have evolved since then, the major branches of their evolutionary tree have not changed, explained astrobiologist Roger Buick at the University of Washington in Seattle in an announcement of his research. “For microbes, it appears that almost all of their major evolution tool place before we have any record of them way back in the dark mists of prehistory,” he said.
It won’t be easy for scientists to adapt their growing knowledge of microbial chemistry for human practitioners. But a new field of science-based engineering is being born: metabolic engineering.